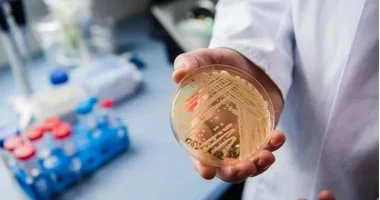
دراسة: دواء للضغط الدم يقضي على بكتيريا مقاومة للمضادات الحيوية

دراسة: دواء للضغط الدم يقضي على بكتيريا مقاومة للمضادات الحيوية
تُعد مقاومة البكتيريا للمضادات الحيوية تحديًا صحيًا عالميًا خطيرًا، حيث تؤدي إلى صعوبة بالغة في علاج العدوى. تشير الإحصائيات إلى أن هذه العدوى مسؤولة عن ملايين الإصابات والوفيات سنويًا في الولايات المتحدة وحدها، مما يستدعي البحث عن حلول علاجية مبتكرة وفعالة.
في خطوة تبعث على الأمل، كشفت دراسة علمية حديثة عن اكتشاف طبي واعد قد يغير وجه علاج بعض أنواع البكتيريا المستعصية. فقد أشارت نتائج الدراسة، التي نُشرت في مجلة “نيتشر كوميونيكيشنز” المرموقة، إلى أن دواءً شائع الاستخدام حاليًا لخفض ضغط الدم، قد يمتلك القدرة على أن يصبح أساسًا لعلاج جديد وفعال ضد بكتيريا المكورات العنقودية الذهبية المقاومة للميثيسيلين (MRSA).
فهم طبيعة بكتيريا المكورات العنقودية الذهبية المقاومة (MRSA)
“تُشكّل بكتيريا MRSA خطرًا حقيقيًا، فهي تنتشر في كل من البيئات الطبية والمجتمعية، وتتسلل إلى الأجسام بطرق متنوعة”، يوضح الدكتور إليفثيريوس ميلوناكيس، المؤلف الرئيسي للدراسة ورئيس قسم الطب بمستشفى هيوستن ميثوديست. ويضيف: “قدرتها على البقاء والتكاثر حتى في وجه المضادات الحيوية تجعل السيطرة عليها أمرًا صعبًا للغاية.”
في ظل هذه التحديات، يبحث المجتمع العلمي العالمي عن بدائل فعالة للمضادات الحيوية التقليدية. ويشير الدكتور ميلوناكيس إلى أن التكلفة العالية والوقت الطويل المطلوبين لتطوير أدوية جديدة دفع فريقهم لاستكشاف إمكانية إعادة توظيف الأدوية المتوفرة والمعتمدة بالفعل لأغراض علاجية أخرى. كان الهدف هو تحديد ما إذا كانت هذه الأدوية القديمة يمكن أن تمنحنا أسلحة جديدة ضد العدوى البكتيرية.
تركزت جهود الباحثين على فهم كيفية تفاعل الأدوية الموجودة مع الأغشية البكتيرية. فإذا أمكن لهذه الأدوية تغيير الخصائص الفيزيائية لهذه الأغشية، فقد يؤدي ذلك إلى إضعاف البكتيريا وجعلها أكثر عرضة للعلاج. ومن خلال هذه المسارات البحثية، برز دواء معروف وغير مكلف، يُستخدم بشكل روتيني في علاج ارتفاع ضغط الدم، كمُرشح واعد يمتلك هذه الإمكانية الفريدة.
نتائج الدراسة وتفاصيل الاكتشاف
نجح الباحثون، بقيادة الدكتور ناجيندران ثارمالينجام، المؤلف الأول للدراسة، في إثبات فعالية هذا الدواء ضد بكتيريا MRSA في بيئة المختبر. وقد تم ذلك من خلال قدرته على تعطيل الغشاء الخلوي للبكتيريا والتدخل المباشر في وظائفه الحيوية.
لم يقتصر تأثير الدواء على دوره في القضاء على بكتيريا MRSA في مختلف مراحل نموها فحسب، بل إنه قلل أيضًا من قدرتها على تكوين ما يُعرف بـ “الأغشية الحيوية”. هذه الأغشية هي تجمعات بكتيرية متينة تشكل حاجزًا يصعب اختراقه وعلاجه بالمضادات التقليدية.
من خلال إضعاف قوة البكتيريا ووقف تكاثرها، أثبت هذا الدواء أنه يمتلك القدرة على أن يكون أداة قيمة ضمن مجموعة خيارات العلاج المتاحة لمكافحة العدوى البكتيرية المقاومة للمضادات الحيوية، مما يفتح آفاقًا جديدة في مجال الصحة العامة.


تعليقات